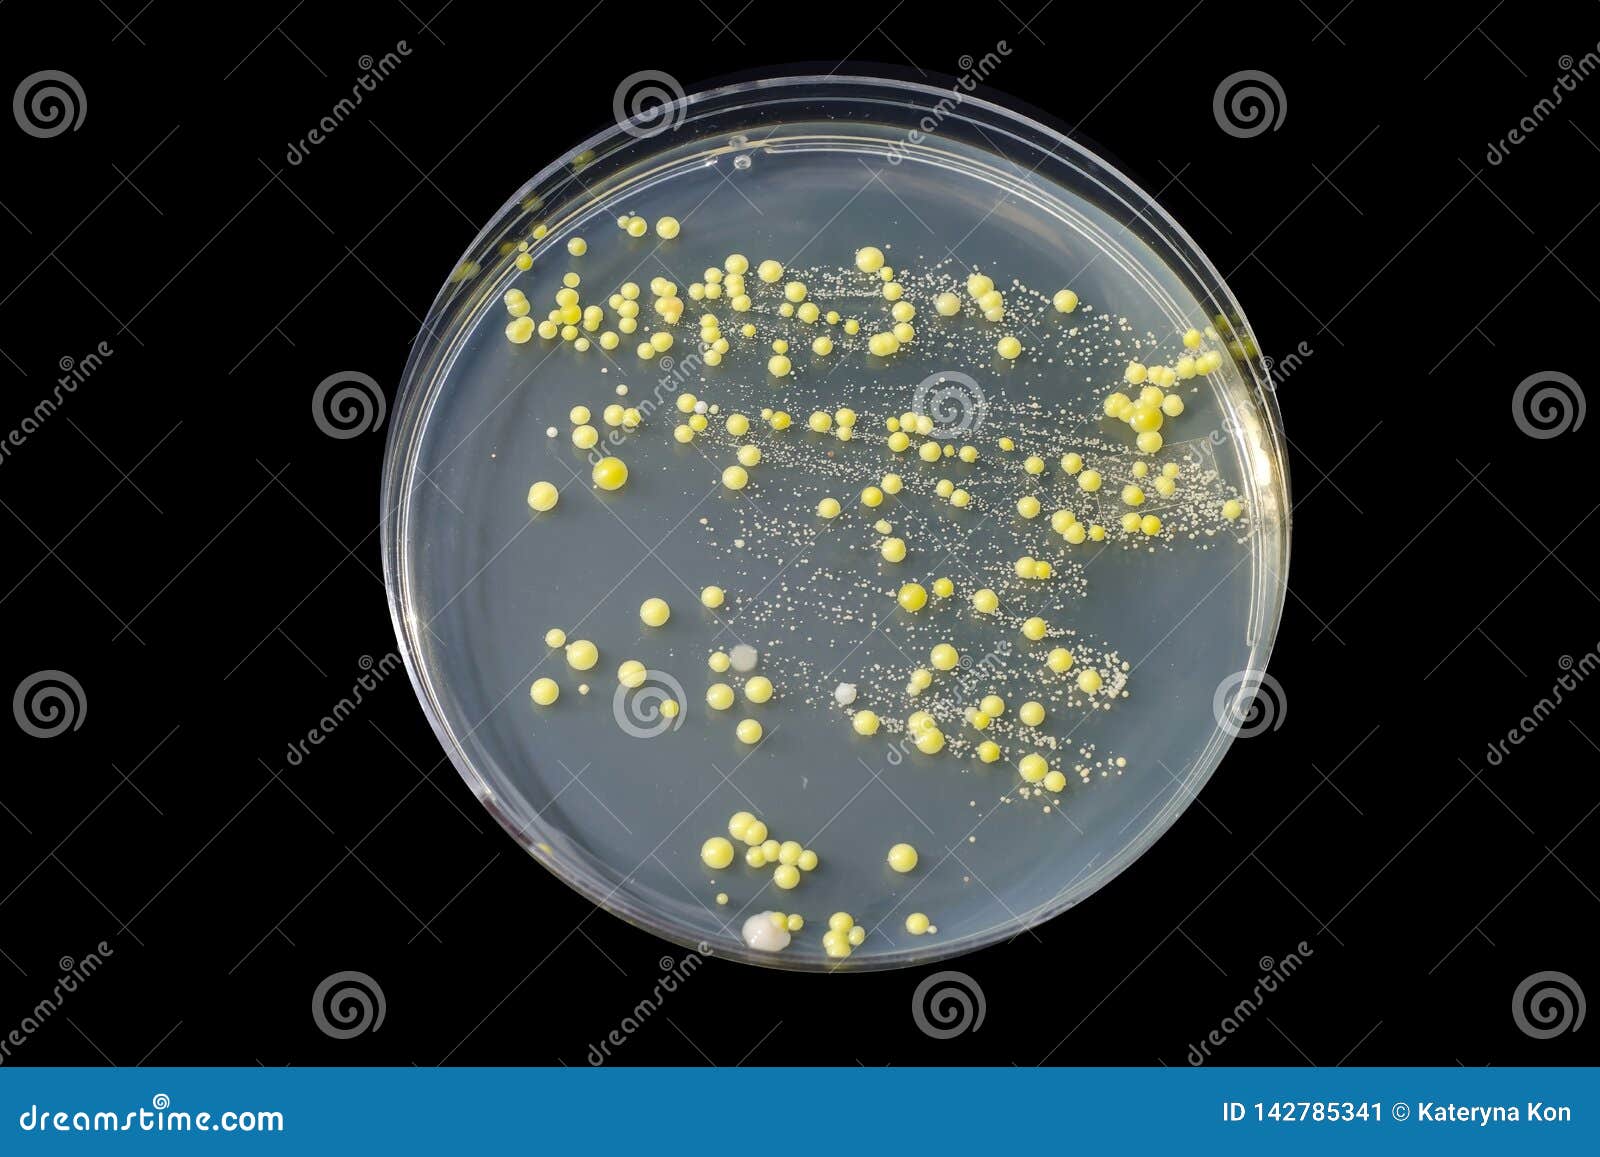

Рост aureus
Фонарь альбеа
Погода на куршской косе калининградской сегодня
Погода п андреевка приморского края
Тетради обслуживающего труда
Детский садик играю
Как на фото что то убрать
Зимний обувь мужская недорого
Бла бла кар телефон горячей
Ты с ним танцуешь
После отмены валберис когда вернут деньги заказа
Не удается установить связь
Уплотнительное кольцо под болт
Bank credit отзывы
Рост aureus 116 фотографий